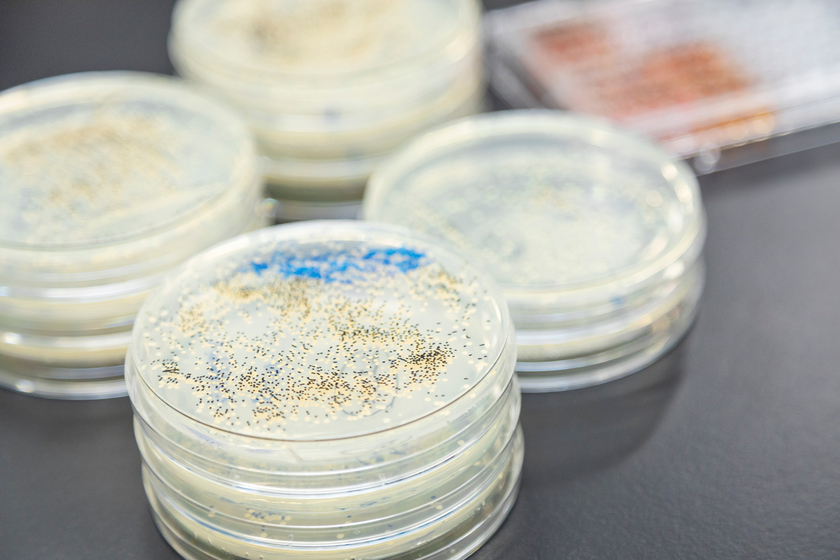

世界中で問題となっている、抗菌薬が効かない細菌(薬剤耐性菌)。2050年にはその感染症により亡くなる患者数が、ガンを超える試算が出ています。これを防ぐためにも本研究室では、実際の患者さんから分離された細菌の病原性や薬剤耐性を解析しています。さらに、研究結果を現場の医師や薬剤師にフィードバックし、感染症と薬剤耐性菌の広がりを防止し、より適正な薬物治療を実践するための研究を行います。また、臨床微生物学教室では、薬剤耐性菌の研究を通して、感染症に強い薬剤師を育成しています。薬剤耐性菌は抗菌薬の不適切な使用によって出現するため、抗菌薬の適正使用の知識が重要です。教室に所属する学生は、解析・研究を経て、卒業時には感染症に強い薬剤師に成長し、医療機関、行政、製薬企業、大学や研究機関などで活躍しています。
本学近隣の9つの病院の感染症患者から分離された薬剤耐性菌を収集し、ゲノムレベルで解析しています。
中南先生が率いる臨床微生物学教室では、医療機関から実際の感染症患者の検体を分与して貰い、生化学的手法で菌を分離・同定し、遺伝学的手法で薬剤耐性や病原性を調査している。ゲノム解析が身近になった今は、薬剤耐性菌をゲノムレベルで解析することでその由来(流行している国や地域)が明らかになり、感染経路を推定することができるのだそう。さらに薬剤耐性菌に有効な抗菌薬を明らかにし、得られたデータは病院にフィードバックを行っている。「研究成果を社会・医療に還元し、人々の安全と健康に貢献します」と中南先生。

教室には感染症に興味を持つ学生が多く在籍しています。普段も活発なコミュニケーションが行われています。
色々なことに受け身にならずに、自分で考え能動的に行動して欲しいですね。そして、なぜその大学に入学したいのか、将来像や夢を思い描いてみてください。明確なビジョンをもって志望校を選ぶことをお勧めします。
専門:細菌の病原性と薬剤耐性に関する研究
略歴:2009年3月東京薬科大学薬学研究科薬学専攻博士後期課程修了。同年4月より東京薬科大学薬学部医療薬学科病原微生物学教室助教。現在、東京薬科大学薬学部臨床微生物学教室教授。
著書:『在宅医療・介護における感染管理ハンドブック』宇宙堂八木書店(2018)、『スタンダード薬学シリーズII 生物系薬学III. 生体防御と微生物』東京化学同人(2016)ほか。
※この画面の情報は、すべて取材した時点でのものになります。



